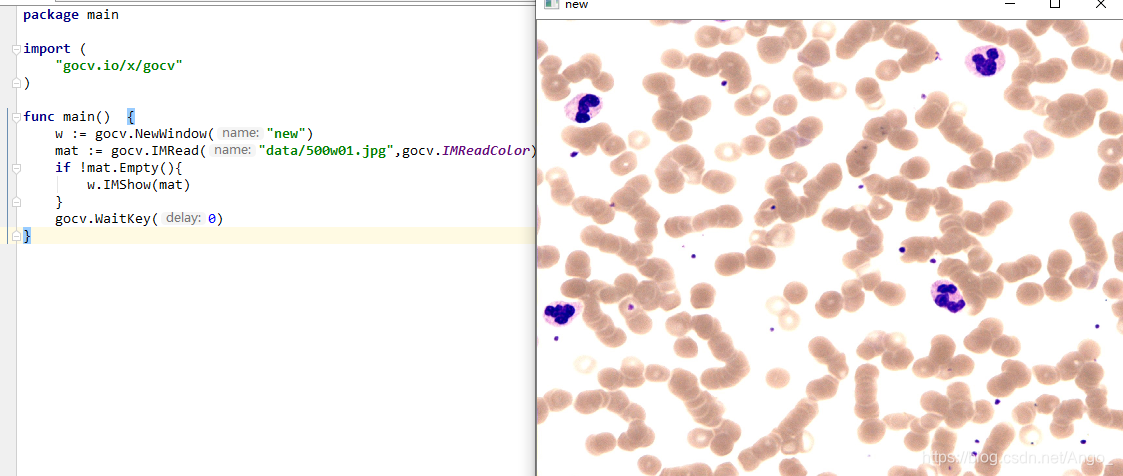
结果

GoCV golang版opencv测试(Windows)
GoCV
GoCV是go语言版的opencv封装,基于opencv4.0+
项目地址:https://gocv.io/
环境配置
配置可参考官网教程
https://gocv.io/getting-started/windows/
OpenCV编译
过程中opencv是需要我们自己编译的,opencv的编译将耗时1个小时左右。
可以从这里下载我编译好的版本直接使用:
https://download.csdn.net/download/Ango_/12387727
将压缩包解压到c盘根目录即可。头文件目录为 C:\opencv\build\install\include
注意MingW版本为:mingw64-x86_64-8.1.0-release-posix-seh-rt_v6-rev0,
可自行google下载,也可以从这里下载:
https://download.csdn.net/download/Ango_/12101841
测试
环境配好之后直接上代码测试:
// 打开图片
package main
import(
"gocv.io/x/gocv"
)
func main(){
w:=gocv.NewWindow("new")
mat:=gocv.IMRead("data/500w01.jpg",gocv.IMReadColor)
if!mat.Empty(){
w.IMShow(mat)
}
gocv.WaitKey(0)
}
效果:
// 打开摄像头
func main(){
w:=gocv.NewWindow("new")
c,err:=gocv.VideoCaptureDevice(0)
iferr!=nil{
panic(err)
}
im:=gocv.NewMat()
for{
c.Read(&im)
w.IMShow(im)
w.WaitKey(1)
}
}
效果:


浙公网安备 33010602011771号